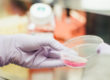

Bei der Analyse wird ein Tropfen Blut im Dunkelfeldmikroskop untersucht. Dieses Verfahren zeigt uns weitaus mehr als ein herkömmliches Blutscreening.
Ziel der Diagnose ist es, die Anzahl und den Wachstumsgrad der Mikroorganismen im Blut festzustellen, sowie den Zustand einzelner Organe, Organsysteme und Körperregionen zu erkennen. Dadurch finden wir häufig die Krankheiten, lange bevor diese ausbrechen und zu Beschwerden führen. Auch der Verlauf der an- gewandten Therapie, ist somit gut zu beurteilen.